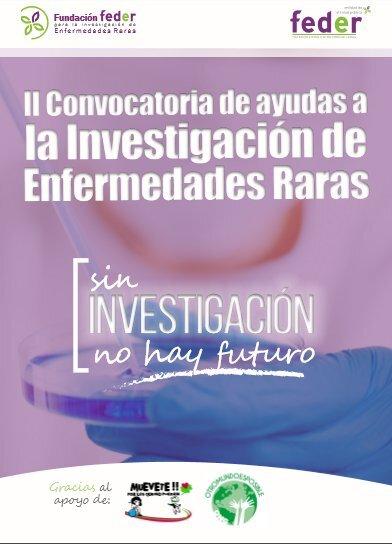

CONVOCATORIA DE
Accede a las bases de la II... Accede a la resolución de la II...Resolución
- Fondos de la convocatoria: 16.000,00€
- Nº de proyectos beneficiarios: 2
Conoce los Proyectos beneficiarios
- Análisis sistémico de la red génica de especificación y mantenimiento del epitelio pigmentario: hacia nuevas terapias para la retinosis pigmentaria.
- Estudio de las bases genéticas del albinismo.